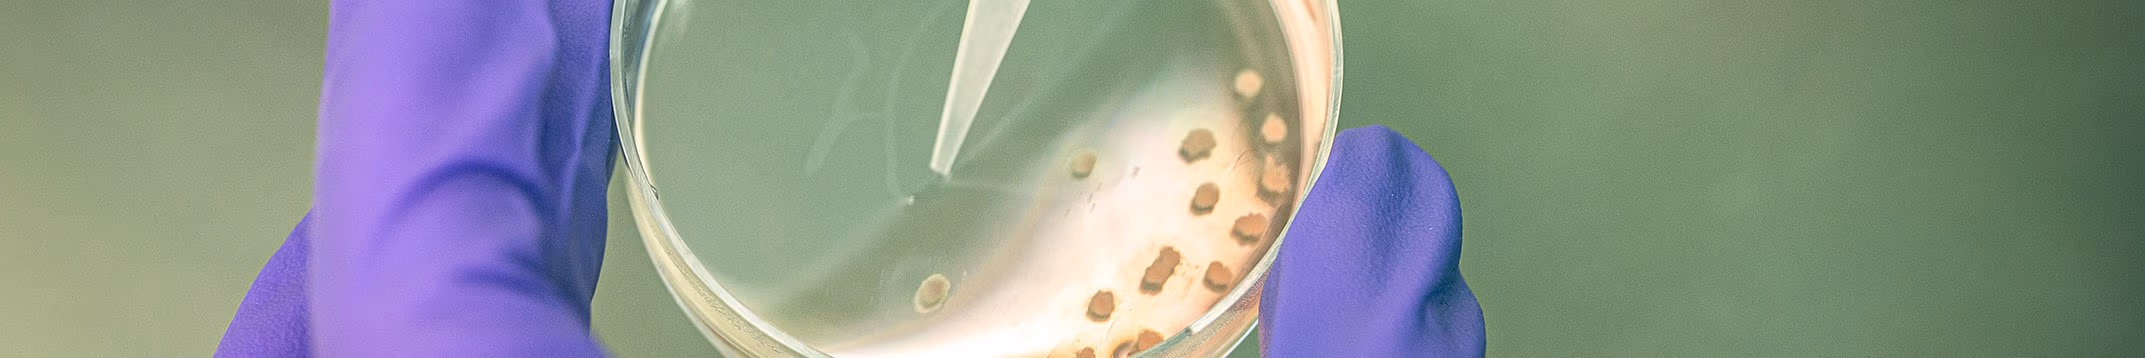

The Netherlands aims to become an international frontrunner in creating innovations that make animal testing obsolete. For this reason, the national government is encouraging the development and application of research methods that do not involve animal testing. This is being conducted through the partner programme Transition Programme for Innovation without the use of animals.
-
Why TPI: mission, vision and objectives
-
What TPI does: conducting dialogue and sharing knowledge
The partners behind TPI
TPI's partners come from government, society, business and science. We sometimes think differently about the transition to animal-free innovations and have different knowledge in-house. In this way we inspire each other and complement each other.
We all want a safer world for humanity, animals and the environment (animated video)

Transition to Animal-free Innovation...
...abbreviated as TPI is a programme designed to enhance the transition to animal-free research.
A partner programme in which ministries
join forces with other organisations.
We all want a safer world for humanity,
animals and the environment.
That includes animal testing.
However, there is much debate about animal testing, because of the animal suffering...
...and because the results are not always
applicable to humans.
After all, a rabbit differs from a human being.
In some cases, research on human cells,
human tissue or human data,
provides better answers to questions
about the human body.
Our mission is therefore to achieve better
prediction without animal testing.
But animal-free innovation does not simply mean replacing an animal test with another method.
Let us explain.
Animal testing is constantly being improved
using the three R’s:
Replacement where possible,
Reducing the number of animals where possible,
and Refining techniques to improve animal welfare.
You might be thinking:
replacing animal testing,
surely that’s enough?
Yes, that would be ideal.
But TPI takes a wider view:
What is the societal issue we are trying to solve?
What research question do we need to ask?
And how can we find the best answers?
New methods can often be a great way forward,
for example:
Cells in a petri dish,
Cells working together as a mini-organ,
Computer programs that calculate
test data from patients,
or a combination.
But how can we be sure that these
new methods are effective?
Instead of comparing them to animal testing,
which is less reliable,
we compare them to reliable data on humans.
At present, some types of research still
need to use animal testing.
But as more animal-free innovations emerge,
this need will gradually decrease.
As long as animal testing exists,
we must continue to use the three R’s.
In the meantime, we are doing all we can to accelerate the transition through:
information, communication, grants,
meetings and events, networks and projects.
TPI involves a major system change.
We need everyone to be part of that process:
researchers, lecturers, patients,
animal welfare groups,
businesses, administrators, politicians,
lawmakers and a host of others.
We need to join forces to make
this transition happen.
That means pushing boundaries
and making connections.
The transition is already in full swing!
Do you want to help?
*Logo TPI appears*
TPI in stories
The TPI programme is broad. A lot of people are involved. We share their stories to discover the opportunities and concerns regarding animal-free innovation.
Martijn Nolte
“We need both animal-free and animal-wise testing methods to make the transition.”
Interview with Martijn Nolte, senior programme manager for More Knowledge with Fewer Animals (MKMD) at ZonMw.
Nynke Kramer
‘Feel free to call it old-fashioned academic nerdiness, but I always get a thrill when a new model works’,
Interview with Nynke Kramer, toxicologist at the WUR about computer models for toxicological research
TPI initiatives
The TPI partners are developing initiatives to accelerate the transition. The broader network is also working on animal-free innovations.
Centre for Animal-Free Biomedical Translation
Ombion is a national centre for valorising and disseminating animal-free innovations and expertise. It aims to improve and accelerate the transition of new biomedical innovations to patients and users, without the use of animals.
NAMs databases: sharing knowledge and expertise on animal-free research
NAMs databases support researchers and other stakeholders with structured overviews and make expertise and knowledge on animal-free innovations more accessible and easier to navigate.
Milestones towards animal-free innovations
The Netherlands aims to become a driving force in accelerating the transition involving biomedical research and clinical drug trials without using animals. The (partners in the) Transition Programme towards Innovation without the use of laboratory animals have a slogan that says it all: Better predictions without the use of animals. The timeline provides an overview of the developments required in order to achieve that aim.
Scientists William Russell and Rex Burch introduce the principle of the 3Rs. This inspires developments in the area of reduction and refinement, as well as replacement of animal experiments (or alternatives to animal use) across the globe. In 1977, the Netherlands, using the 3Rs as a basis, introduces the Experiments on Animals Act (Wet op de dierproeven) (Wod).
The 3 Rs stand for:
- Replacement: Replace animal experimentation with a method that does not involve live animals;
- Reduction: Use no more laboratory animals than is necessary;
- Refinement: Avoid pain or distress in laboratory animals as far as possible.
Welfare of laboratory animals
The 3Rs improve the welfare of laboratory animals. They also promote the development of alternatives to animal testing. In the Netherlands, the 3Rs are laid down in Section 1d of the Experiments on Animals Act (in Dutch).
Russell and Burch describe 'The Three Rs’ in the study entitled The Principles of Humane Experimental Technique' (November 1958).
The Experiments on Animals Act is the first Act in the Netherlands to contain rules on the use of laboratory animals. The 3Rs play an important part in it: replace, reduce and refine the use of laboratory animals.
Protection of laboratory animals
The Experiments on Animals Act (in Dutch) protects laboratory animals. For instance, experiments using live animals are now permitted only where there is no alternative. Experiments that cause serious pain, fear, suffering or lasting injury to animals are prohibited. Where it is necessary to use live animals, pain, suffering, fear and lasting injury must be avoided or kept to a minimum. In addition, where possible, experiments on animals must take place under general or local anaesthesia.
The PAD coordinates and promotes research into 3R alternatives to animal testing, including through the use of grants. Within this platform, civic organisations, research institutions, the government and the business community work together on solutions.
The PAD has the following three tasks:
- To promote research;
- To advise the relevant ministers;
- To promote policy for alternatives.
PAD advisory body
In 1997, the PAD becomes an advisory body. It is joined by a representative from the scientific community. The Netherlands Organisation for Health Research and Development (ZonMw) takes over the grant activities. ZonMw finances health research and promotes innovation in healthcare. The PAD advises the Minister of Welfare, Public Health and Culture (WVC) on the ZonMw programme entitled Limits to Animal Testing (Dierproeven Begrensd).
Animals have an intrinsic value, a value in and of itself that is independent of its value or use to humans. The addition of this sentence to Section 1a of the Experiments on Animals Act (Wod) (in Dutch) is intended to strengthen the position of laboratory animals.
Protect animals
The government now clearly states that animals must be protected and not serve only as a tool for humans.
The central government promotes the development of alternatives to animal testing. The suffering of animals which are still required for animal experiments must be kept to an absolute minimum. Scientists receive funds from the Dierproeven begrensd grant programme to enable those objectives to be achieved and alternatives to animal testing developed.
Grants for research into alternatives to animal testing
Between 2000 and 2011, on behalf of the central government, the research funder ZonMw provides grants for, among other things:
- the development of the website humane-endpoints.info for the training of professionals who work with laboratory animals;
- research into the efficacy and safety of vaccines which involves no or less animal testing;
- the improvement of the housing, feeding and treatment of laboratory animals.
The government aims to reduce the number of animal experiments and sets up the National Knowledge Centre for Alternatives to Animal Use (NKCA). This centre provides training and shares knowledge on, among other things, alternatives to animal testing.
Political agenda
The publication of the government's view on Alternatives to Animal Testing (6 June 2008) (in Dutch) puts the subject higher on the political agenda. The organisational structure for the implementation of the policy is amended. The NKCA supports the Interministerial Working Group on Alternatives to Animal Testing (IWAD), and a stakeholder focus group contributes expertise from the business and scientific communities and society.
Experimental research using animals is expensive, difficult to replicate and often complex. Those are the main conclusions from a study carried out by ZonMw on behalf of the central government.
Advantages of alternative methods
Animal experiments are no longer necessarily the best method ('gold standard’) for fundamental, applied and statutory research. Alternative methods have many advantages:
- they can be replicated (are reproducible);
- they better predict effects on humans;
- they are ethically less contentious, and
- are more cost effective, producing the same or better results at the same or lower cost.
More effective direction
This is stated in the Scientific Trend Analysis on Animal Procedures Report (December 2009) (in Dutch) of Utrecht University. It is the first systematic analysis of developments regarding laboratory animals, animal testing and alternatives. The central government can use it to direct policy and funding for alternatives to animal testing more effectively. The Social Trend Analysis on Animal Testing is published simultaneously with this study.
Businesses and researchers continue to use animal experiments. Only external pressure can change this. Those are the main conclusions of a study conducted by the Athena Institute and the Vrije Universiteit Amsterdam (VU Amsterdam).
Reasons for using animal experiments
Scientists, industry and bodies that assess medicinal products continue to favour animal testing over alternatives. Some of the reasons for this are listed below, for each of the above categories:
- Industry: a product tested using alternative methods will take longer to receive marketing authorisation;
- Assessors: the evaluation of alternative methods is often more expensive;
- Scientists: there insufficient funding for research into alternatives. Added to this is the fact that scientific journals are less likely to accept publications about alternative testing methods.
New technologies
Promising technologies which could replace animal experiments in the future include
- micro-dosing: testing small amounts of a drug directly on humans;
- micro-array: automated analysis to identify genetic material on a chip.
Public debate, media attention or government rules can also result in new developments. This is mentioned in the two parts of the Social Trend Analysis on Animal Testing study (2009):
The number of animal procedures could be reduced to 40% by 2025 if the government invests more in alternative methods, as a study conducted by research funder ZonMw shows.
Three scenarios
This report indicates that there are three potential scenarios that could be enacted by 2025. They depend on how much money the central government invests:
1. Status quo
Investment level remains the same: nothing in the educational environment in which animals are used will change. In this scenario, the use of animals will decrease by less than 1%.
2. Linear
More investments, which will be accompanied by, among other things, new research methods and changes in the learning programme within biomedical education. This will result in a 25% decrease in the number of animals used and less distress caused to the animals that are still required. According to the report, research costs will also fall.
3. Exponential
Rising levels of investment, which will be accompanied by training courses on new research methodologies for employees of universities, the government, regulatory bodies and the business community. The report states that this will result in a decrease of at least 40% in the number of animals used.
Read more in the Business Case for Alternatives to Animal Testing: ‘More Knowledge with Fewer Animals' (Meer Kennis met Minder Dieren), (16 November 2010) (in Dutch) produced by ZonMw.
There is room for improvement in the Replacement, Reduction and Refinement (3Rs) of animal experiments. One way for such improvement to be brought about would be to arrange closer cooperation between the central government and the bodies that authorise drugs, for example, with the developers of 3R methods. This chain-based approach for alternatives to animal testing is one of the recommendations in a study conducted by the National Institute for Public Health and the Environment (RIVM).
Promising areas for the 3R
RIVM also indicates a number of areas where the promotion of 3R methods would be likely to succeed. Examples include research into:
- cancer and other diseases;
- medicines;
- harmful substances.
This is set out in the two parts of RIVM's Planning study for Alternatives to Animal Testing:
The number of animal experiments can be reduced further. The central government describes the approach to be used for this in the Action Plan for reducing the number of animal experiments.
Activities
The action plan names various activities that can be used to reduce the use of animal experiments. They include:
Education
Trainee research assistants could include additional supporting information in their theses showing why a particular animal experiment cannot be dispensed with. They should also specify what they have done to replace, reduce or refine the experiment.
Research
Systematic literature reviews could enable scientists to produce a very comprehensive inventory of the research already conducted (including any animal experiments) in their areas before starting a new research project. This would avoid any unnecessary use of animals, and identify possible alternatives and the best model to use for the research topic.
Sharing knowledge
Representatives from the scientific community, policy and industry, among others, will share their knowledge in what are known as round-table discussions. This should lead to a reduction in animal experiments.
Read more in the 2011-2021 Animal Experiments and Alternatives Action Plan (in Dutch) of 30 December 2011.
Funds for the development of new methods for research without the use of animals and for the improvement of existing methods. This is provided by the MKMD set up by ZonMw, which funds the programme.
Better health and healthcare
The ultimate goal of the MKMD programme is better research into human health and healthcare. The programme comprises several modules. Each has its own objectives, framework conditions, cooperation partners (where applicable) and grant rounds.
Read more about the MKMD programme on the ZonMw website.
It is possible to reduce the number of laboratory animals used. However, the impact of investments made to that end will not be seen until after 2025, as a follow-up study carried out by the Technopolis Group consultancy agency shows.
Technopolis calculated the impact based on the ZonMw's Business Case for Alternatives to Animal Testing (16 November 2010) (in Dutch). Below are some of its conclusions:
- The 2010 business case overestimated the decrease in the number of animal experiments.
- The impact of investments will not be seen until after 2025, and it will not be until then that it will be possible to make optimum use of the methods.
- It would therefore appear that it will not be possible to reduce the number of animal experiments until after 2025.
- International acceptance of the 3Rs (Replacement, Reduction and Refinement of animal experiments) by colleagues and in rules is uncertain.
- The investments set out in the business case may accelerate the reduction in the number of animal experiments if the government uses the funds in an effective, coordinated and focused manner.
Read more in the Analysis of the Business Case for Alternatives to Animal Testing (10 July 2014) (in Dutch).
From now on, you may use animals for scientific research only when there is no alternative. The central government introduces this EU Directive in the Netherlands with the amended and revised Experiments on Animals Act.
The Experiments on Animals Act provides greater protection for laboratory animals
It contains rules which go further than the Directive. The 3Rs play an important part in it:
- Replacement: Replace animal experimentation with a method that does not involve live animals;
- Reduction: Use no more laboratory animals than is necessary;
- Refinement: Avoid pain or distress in laboratory animals as far as possible.
With the enforcement of these rules, the Netherlands also protects the welfare of laboratory animals to a high level.
Read more about the amendment in the Animal Experiments Decree 2014 (Dierproevenbesluit 2014) and the Experiments on Animals Act in effect from 1 July 2021 (both in Dutch).
Thorough searches of, among other literature, scientific publications (systematic reviews) could reduce the number of animal experiments, according to a report produced by the Tabula Rasa research agency.
Embed in education
There remains a lack of emphasis on systematic reviews in medical and biomedical training programmes. Students must therefore learn to carry out systematic literature reviews before starting a new research project. This will avoid the unnecessary use of animal experiments. The report also recommends that literature reviews should be a component of government-funded research.
Read more about Tabula Rasa's recommendations in the report entitled Systematic Reviews in the area of animal experiments (in Dutch) of January 2014.
Thorough searches of earlier publications (systematic reviews) may help bring about better science. Researchers will also be less inclined to opt for the use of laboratory animals. This is borne out in a survey conducted by the Tabula Rasa research agency.
More information and help
More than half of those participating in the survey indicate that they would like more information and help. Employees who have not yet obtained their doctorates, in particular, need skills training in order to be able to carry out systematic reviews on their own.
Lack of time and knowledge
Researchers give various reasons for not carrying out literature reviews:
- insufficient time or priority;
- insufficient knowledge to search the literature concerned;
- terms of reference where literature reviews would serve no useful purpose.
Read more in the survey entitled Systematic reviews for animal studies in education and research at Dutch universities and university medical centres (March 2015) (in Dutch).
The central government can increase the pace of the transition to animal-free research. This will require a change in the way we think, act and organise. This is stated in a report by the Think Tank on Supplementary Financing for Alternatives to Animal Testing.
Recommendations in the report
Below are some of the recommendations set out in the report:
- Publish negative research results as well: this will spare laboratory animals in new research projects;
- prepare a list of animal-free research to highlight inspiring examples;
- start a fund that will support the development of alternatives to animal testing;
- start a network for pioneers in animal-free innovation.
Read more in the report entitled In transition! (October 2015) (in Dutch).
The central government could replace some of the regulatory safety testing involving animals of medicines and chemicals, for example, by 2025. This is the conclusion of The Netherlands National Committee for the protection of animals used for scientific purposes (Nationaal Comité dierproevenbeleid (NCad)) in an opinion produced for the government.
Use of new technologies
Animal testing remains mandatory According to the NCad, new technologies could in time replace animal testing. Examples include cells-on-a-chip that simulate a liver, or computer models that can predict the effect of particular substances.
The Netherlands as the driving force
The Netherlands could be the international driving force in innovations without laboratory animals by 2025. According to the NCad, ways in which this could be achieved include:
- reducing the number of animals used in biomedical and veterinary education;
- providing education and training in alternative methods for scientists;
- replacing animal testing with research using human cellular and other material.
According to the NCad, the central government is the only party that can manage the process.
Read more in the NCad's opinion entitled Transition to animal-free research (Transitie naar proefdiervrij onderzoek) (December 2016) (in Dutch).
The Netherlands must be world leader in accelerating the transition to animal-free research methods by 2025. That is what Martijn van Dam (Economic Affairs) says in a letter to Parliament.
Alternatives to animal testing
The central government will promote the development of alternatives to animal testing using, for example:
- RIVM's milestone plan: with specific targets to reduce the number of laboratory animals;
- a network of animal-free Innovation Pioneers: which will be used by leading scientists, innovative businesses and civic organisations to exchange knowledge about alternatives to animal testing.
Read more in the letter to parliament concerning Animal Experiments (15 December 2016) (in Dutch).
The Dutch government must take significant steps to ensure that our country becomes the frontrunner when it comes to animal-free innovation. This is one of the conclusions from a round table discussion between stakeholders and Parliament.
Animal-free innovation
Various parties inform Parliament regarding the areas where animal-free innovation will or will not be possible. The discussions are divided into four blocks:
- The importance of animal-free methods and the position as regards animal-free technologies. Examples include computer simulations or the use of human tissue.
- How non-governmental organisations (NGOs) cooperate and contribute to the transition to animal-free research.
- Recommendations on the development of animal-free innovations and how they can be introduced.
- The usefulness of animal testing in reducing health risks, and how such tests could be replaced.
Read more in the position papers for the Development of Animal-Free Research Methods round table discussion (14 September 2017) (in Dutch).
Determine, without animal testing, whether chemicals and drugs are safe for humans. To that end, the RIVM research institution prepared a roadmap for its work for the central government.
Assess safety without using laboratory animals
According to RIVM, this will require:
- consciousness-raising: for example, with regard to when a substance is safe and how it can be tested without using animals;
- laws and rules permitting animal-free safety assessments
- safety assessments that are based on the biology of the human or the target animal;
- list of animal-free innovations: examples include computer models, cultured cells and the measuring of substances in urine, blood or hair (biomonitoring)
- information portal and network organisations: for the development and implementation of animal-free innovations at regional, national and international levels.
Read more about the Roadmap for animal-free innovations in regulatory safety assessment (PIRV) (March 2018) or in the Agenda proefdiervrije innovaties in het regulatoire veld (in Dutch).
The central government intends to increase the pace of animal-free innovation. Various public authorities, scientific organisations and civic organisations will work together to make that intention a reality within the TPI partnership programme. The partners' ambition is to ensure that the Netherlands becomes the driving force in the international transition.
Networks for new ideas
The TPI will ask scientists and other experts to come up with ideas for animal-free innovations and try them out within innovation networks. This will include:
- creating rules for the safety of animal-free methods;
- discussing the needs of businesses: identifying the challenges they will face when marketing their animal-free innovations;
- making animal-free innovation and the importance thereof more understandable to the public.
Read more about the Transition to Animal-Free Innovations: Philosophy and Method (Proefdiervrije Innovatie, Filosofie en werkwijze) (4 June 2018) (in Dutch).
Reasons for the TPI
Some of the reasons mentioned by the government for the partnership programme:
-
ethical and social concern regarding the welfare of laboratory animals;
-
limited predictive value of animal experiments;
-
opportunities for animal-free innovations, such as marketing drugs faster and for less money.
Read more in the letter to parliament concerning the Transition Programme for Innovation without the use of animals (TPI) (1 June 2018) (in Dutch).
How can animal-free methods help to combat human diseases? That is the central question in the first TPI Helpathon held in November 2018 at the Netherlands Burns Foundation (Nederlandse Brandwonden Stichting).
Burn in a test tube
How can burns and the circulation of blood in the area surrounding a wound be examined without the use of animals? Burns researchers, Amsterdam UMC, healthcare professionals and pharmaceutical company Pharming devised a solution that involves burns being simulated on human skin in a test tube and examined.
Creative solutions
During a ‘Helpathon’, teams think up creative solutions for a single central question raised by someone planning to conduct animal-free research. The events are derived from 'hackathons', the purpose of which is to develop software or hardware in a short time. 'Helpathon' is a portmanteau derived from the words 'help' and 'marathon'. In the meantime, ‘Helpathon’ has become a term in its own right, and several have been held successfully.
Read more about the results of this and other Helpathons.
Over 100 professionals put on the agenda and discuss ideas for the promotion or assessment of research and testing methods without the use of animals. That is the purpose of the first wide-ranging network event regarding the Transition Programme for Innovation without the use of animals (TPI) on 11 March 2019 at the LUMC in Leiden.
Creative solutions
It is attended by representatives from the entire chain, including scientists, policymakers, research funders, and representatives of business and civic organisations. They meet up in what is known as an 'open space'. This is a form of discussion where each participant can put items for discussion on the agenda and share insights. Spontaneity and chance often lead to creative solutions or new partnerships, something that will often happen during a coffee break.
Watch the video impression of the TPI Open Space in Leiden.
Biomedical Scientists from the knowledge centers in Amsterdam, including Amsterdam UMC, the Vrije Universiteit Amsterdam, the University of Amsterdam and Academic Center for Dentistry (ACTA) meet to discuss what was happening already in Amsterdam regarding animal free innovations and to make a “Plan of Action”
Theme groups
Action points are divided into Theme groups such as Education, Symposia and Networking, Organoid models, Transparency in Animal Research in Amsterdam, Funding Acquisition and Societal Impact.
2024: Amsterdam 4Rs Centre
In February 2024 TPI Amsterdam becomes part of the new Amsterdam 4Rs Centre. Aim is to contribute to the transition to animal-free research by conducting high-quality research with attention to 4Rs (Reduction, Replacement, Refinement of animal experiments and Reproducibility of animal free methods).
Read more about the Amsterdam 4Rs center and Amsterdam TPI (in Dutch)
At present, brain research cannot be carried out without the use of laboratory animals. This is the conclusion of the Royal Netherlands Academy of Arts and Sciences (KNAW) based on an inventory prepared by its members.
Mix of methods and technologies
Innovative methods for neuroscience research are also discussed in the inventory. The KNAW concludes that animal-free methods and technologies may develop further over the next 10 years. However, animal-free research alone will be unable to answer the key research questions. They will continue to require research involving a mix of methods and technologies.
Read more about KNAW publications in:
- Inventory: 'The importance of animal testing and how it can be curtailed in basic neuroscience research' (Inventarisatie 'Het belang van dierproeven en mogelijkheden tot vermindering daarvan in fundamenteel-neurowetenschappelijk onderzoek’) (19 July 2019) (in Dutch);
- Excellent brain research involving fewer animal experiments (Excellent hersenonderzoek met minder dierproeven) (19 July 2019) (in Dutch).
By 2040, all Dutch people will live at least five years longer, in good health. To this end, the central government is promoting, among other things, innovations in the top sector for Life Science & Health.
Research into chronic diseases
Research into chronic diseases and dementia will also be important here. As yet, there is no cure for dementia. Research using laboratory animals does not appear to be a good predictor of successful treatment in people. That is why it is important that research is conducted based on other technologies, including with the use of human cells or tissue (human measurement models).
Read more about the government's health targets in the Knowledge and Innovation Covenant 2020-2023 (KIC) (15 November 2019) (in Dutch).
Within five to ten years, as many animal experiments as possible will be replaced by research that does not involve the use of animals. This can be achieved by using the milestone plan of The Netherlands National Committee for the protection of animals used for scientific purposes (NCad). Researchers will use it to create a 'target vision' for their field, stating how they intend to go about achieving it and what is feasible on the basis of current knowledge.
Stakeholder consultations
Scientists will consult other stakeholders when preparing their target visions. They include:
- patient organisations
- organisations representing the interests of animals
- transition experts
Preparing a target vision
The target vision will include the following:
- the goal and when it will be achieved;
- the animal-free methods to be used;
- the likelihood of those methods succeeding, and
- the approach to and start of the project.
Scientists have already started preparing target visions for cardiology, immunology and academic and post-academic research.
Read more about target visions for animal-free research on the NCad site.
What is animal-free innovation and how do you go about it? An English-language guide containing examples of 26 companies shows how this works in practice.
The guide also contains articles about the context in which start-ups operate in the Netherlands. It turns out that it is essential that start-ups collaborate with larger companies if animal-free alternatives are to be developed.
Read more in the TPI booklet entitled: 26x better and faster without the use of animals (22 November 2019).
Utrecht hosted 150 professionals from 16 countries in the period between 27 and 29 November 2019 for the international TPI conference (pioneer2policymaker). All those present had one goal in mind: to exchange knowledge and experience in order to quicken the pace of animal-free innovation. The TPI partners show the approach taken by the Netherlands to accelerate the transition.
Prize for animal-free testing
Remco Westerink receives the 2019 Willy van Heumenprijs during the conference. He is head of the Neurotoxicology research group at Utrecht University. He receives the prize for developing animal-free testing using human brain cells cultured on circuit boards.
Read more in the Takeaways of the International conference (pioneer2policymaker) on accelerating the transition to animal-free innovation.
Scientists at the Utrecht Science Park work together to accelerate the transition to innovation without the use of animals. This takes place in the TPI Utrecht working group with leading researchers from biomedical and innovation sciences.
Help Desk
The working group helps researchers and lecturers, for example, with a help desk they can use to contact experts in animal-free research. Helpathons are also held, during which teams come up with creative solutions for a single central problem.
TPI Utrecht
The working group is called TPI Utrecht and it collaborates with the central government's Transition Programme for Innovation without the use of animals.
Read more about TPI Utrecht on the web page Transition to Animal-free Innovations.
Do you, as a professional, need help with animal-free research? Or do you in fact wish to share your knowledge about animal-free innovation? If so, TPI.tv is the place for you.
Videos created for and by professionals
Professionals can post videos on TPI.tv. They can involve colleagues from around the world who are seeking solutions for research that does not involve the use of animals in such videos. Examples include
- scientists, including those from other fields;
- safety assessors, and
- businesses working an animal-free models and tests.
Read more about the online exchange network TPI.tv.
Better predictive health research that is less dependent on animal experiments. That is the objective of the Human Measurement Models research programme. A total in excess of €16 million was made available by research funders and TPI partners for the programme.
Better research says more about people
Research using human cells, tissues or computer models which are based on human data approximate the situation in humans better than animal experiments. For that reason, this programme supports alternatives to animal testing. They include:
- eye-on-a-chip: gain a better understanding and test treatment of eye diseases by using cultured retinal cells of patients;
- computer models: they can be used to better understand brain diseases;
- measurement method that sheds light on the communication between the brain and organs such as the bladder in order to prevent incontinence.
Read more:
- Human Measurement Models, Association of Health Funds (SGF) (in Dutch);
- Human Measurement Models Programme 2.0, Netherlands Organisation for Scientific Research (NWO).
There are many technological innovations that can replace animal experiments. That said, the major revolution is yet to come. That will require breakthroughs in laws and regulations, education and ethics. That's according to the DRIFT research institute.
The transition to animal-free innovation is currently in the phase of pre-development. DRIFT envisages two possible developments which could lead to the wider introduction and acceptance of alternatives:
- personalised healthcare: knowledge about human beings will form the basis of research for human beings. This will replace animal experiments as the 'gold standard'.
- safety assessments: research using humans or human cells is better than animal experiments at predicting the safety of drugs or chemicals. New guidelines based on knowledge about human beings will be required.
Read more:
- Exploring together promising transition paths towards animal-free innovation (Samen kansrijke transitiepaden inslaan naar proefdiervrije innovatie) (2 July 2020) (in Dutch);
- Interview with Jan Rotmans of the Dutch Research Institute For Transitions.
Additional funding for animal-free research into the effects of the coronavirus. This will be provided by the researcher funder ZonMw and the Dutch Society for the Replacement of Animal Testing (Proefdiervrij)
Five coronavirus research projects
The funds will go to five coronavirus research projects:
- Amsterdam UMC: Does heparin inhalation have a preventive effect on blood clots? If so, healthcare staff, for example, would be able to use it to protect themselves in the event of infection.
- Sophia Children's Hospital (Sophia Kinderziekenhuis): it is culturing cells from human airways and blood vessels in order to study the study the emergence and course of viral infections such as COVID-19.
- UMC Utrecht: it is conducting studies using cells of donors to establish the effect of the coronavirus on the nose, lungs, intestines and kidneys.
- University of Twente: it is studying blood clots by using the blood plasma of patients in a model of mini blood vessels on a microchip.
- LUMC: it is conducting analyses to establish how human epithelial cells react to the virus and how that reaction causes lung damage.
Read more:
- Do not allow laboratory animals to suffocate (Laat proefdieren niet stikken): Five animal-free research projects on the coronavirus, Proefdiervrij.nl (in Dutch);
- Animal-free innovations for better COVID-19 research, ZonMw (in Dutch).
The Netherlands is the international frontrunner when it comes to promoting animal-free innovation. This is stated in the self-evaluation of the Transition Programme for Innovation without the use of animals (TPI).
The central government is set to direct the transition to animal-free procedures
What is especially innovative is that the central government will be directing the transition. It is essential that partners from the entire chain are involved if the acceleration of and transition to animal-free research is to take place. The Dutch approach, which includes using the TPI partnership programme, is now also attracting the attention of foreign scientists and agencies.
Three aspects of progress
The progress made in the process leading towards animal-free innovation is measured in three ways:
- a growing network: more scientists, policymakers and business are sharing knowledge about animal-free methods and technologies;
- looking at research proposals differently: this is far less common for laboratory animal research;
- vision on alternatives to animal testing: they often predict better the effects in humans of, for example, medicines and chemicals.
Read more:
A 1% levy on the research budget for animal experiments is not enough to promote research that does not involve the use of animal experiments. Substantially larger investments in alternatives will, however, bring about a fall in the number of animal experiments, as a follow-up study carried out by the Technopolis Group consultancy agency shows.
Poorer science climate
A levy on animal experiments will also lead to a poorer science climate, and may also shift research abroad. The consultancy agency also anticipates that this will diminish support for the transition to animal-free research methods
Read more in the Study on the finances of laboratory animal research and animal-free innovations (Studie naar de financiën van proefdieronderzoek en dierproefvrije innovaties) (13 November 2020) (in Dutch).
Digital 3D animals for anatomy lessons instead of real animals. That was the winning entry for the inaugural Animal Free Venture Challenge. The winner, Avatar Zoo, receives €25,000 to enable it to take its virtual reality models further.
Impact of animal-free research
In introducing the challenge, the Dutch Society for the Replacement of Animal Testing aims to increase and accelerate the impact of animal-free research. It is a programme lasting ten to twelve weeks in which an animal-free scientific breakthrough is converted into a business plan. Teams of researchers are helped to convert their ideas into a successful business.
Read more about the Animal-Free Venture Challenge on the website of proefdiervrij.nl.
Testing medicines and chemicals using computer programs containing human biology data is the idea behind the 'Virtual Human Platform for safety assessment' (VHP4Safety) research project. This could in future be used in place of animal experiments during the present safety assessments.
Predicting the effect of a drug
Researchers are working on a 'virtual human' computer model that can predict the effect of a substance introduced into the body. This could enable better and faster detection of side-effects of medicines, for example. Experts in data science, toxicology, technology, biotechnology and transition science collaborate in the VHP4Safety project.
Read more in the document entitled Towards reliable safety assessment using animal-free innovations (Op naar een betrouwbare veiligheidsbeoordeling met proefdiervrije innovaties) (28 July 2021) (in Dutch).
How do we ensure that existing animal-free models can actually be used? The science funding body NWO makes nearly €3 million available for research that answers that question.
Substance safety
People are exposed on a daily basis to chemical substances in food, cosmetics and the environment. The safety of those substances has to be assessed in order to protect humans. Confidence that this will in time also be possible using animal-free models, based on knowledge about and data on humans, is yet to grow.
Problem solving
A lack of awareness and trust means that acceptance and use of existing animal-free models is slow to grow. Hence the NWO's request that scientists, regulators and the business community jointly come up with proposals to examine solutions to this problem.
Read more about the Dutch Research Agency (NWA)'s call for research regarding the acceptance of animal-free models.
The government intends to go ahead with the programme aimed at increasing the pace of the Transition Programme for Innovation without the use of animals (TPI). It also aims to make the transition to animal-free research easier to discuss. For instance, by sharing stories about the possibilities alternatives have to offer, and by continuing dialogues with parties holding different views.
Increasing the pace of the transition to animal-free research
During this phase of the TPI, the initiatives of all stakeholders should increase the pace of the transition to animal-free research in a targeted manner. The government intends to monitor the acceleration of the transition and ensure that parties holding opposing views continue to discuss the subject with one another.
Read more in the letter to parliament about the continuation in 2021-2023 of the Transition Programme for Innovation without the use of animals (TPI) (21 July 2021) (in Dutch).
It aims to abolish faster laboratory tests using animals. The parliamentarians ask the European Commission (EC), the executive body of the European Union (EU) to provide a plan for this.
Action plan for resolving bottlenecks
In the EU, researchers are already obliged to use non-animal test models where they are available. The Parliament wants an action plan from the EC to resolve bottlenecks surrounding the use of alternatives to animal testing. That action plan should focus on research, prescribed tests for safety assessments and education. The Parliament's ultimate aim is to abolish animal experiments in their entirety. Read more in the European Parliament's Resolution on plans and actions to accelerate the transition to innovation without the use of animals in research, regulatory testing and education (16 September 2021).
Systematic comparison of existing research (systematic review) can improve the quality of laboratory animal research, as shown in a ZonMw study into an eight-year funding programme for systematic reviews.
Better quality of research
It turns out that if they do not conduct literature reviews, researchers regularly use the wrong animal model. Examples include use of the wrong strain of rats. Literature reviews improve the quality of the design and implementation of research and the reporting on it.
Becoming more aware of the impact of research
It has also emerged that researchers will be more aware of the impact of laboratory animal research and animal-free innovations following a literature review. For instance, they will produce better reports on:
- the housing of the animals;
- the treatment selected;
- justification for the use of the animal model.
Literature reviews therefore prevent the unnecessary use of laboratory animals (animal waste) and redundant repetition of research (research waste).
Read more:
- article entitled Systematic literature reviews replace, reduce and refine laboratory animal research (Systematisch literatuuronderzoek vervangt, vermindert en verfijnt proefdieronderzoek) (10 November 2020) (in Dutch), ZonMw;
- English-language article The impact of conducting preclinical systematic reviews on researchers and their research: A mixed method case study (13 December 201 [sic]), PLOS ONE.
Sharing knowledge and contributing to animal-free innovations. This is the goal of Young TPI, a network for students and young professionals.
Animal-free careers
Young people have the opportunity to start their careers without the use of laboratory animals. Young TPI therefore wishes to inform them about all the possibilities at an early stage. They will also share their own experiences in the network, for example so that innovative ideas about animal-free models for research can be disseminated more widely.
Aims of Young TPI
- to contribute to accelerating the transition to animal-free innovation,
- to create awareness and share knowledge about existing innovations,
- to help with career prospects: e.g. by making contact with employers and developing professional skills,
- to advise and communicate on animal-free innovations.
The BATI shows what knowledge institutions are doing in the area of animal-free innovation and the 3Rs: replacing, reducing and refining animal experiments.
Comparing advancements
Knowledge institutions can use the BATI to compare their efforts in the field of animal-free innovation and thus gain new insights.
Advantages of the BATI
- benchmark: compares performance and policy for animal-free research in the Netherlands,
- monitoring: shows how the transition to animal-free innovation is proceeding,
- best practices: shows good examples which others can learn from,
- encourages transparency and cooperation for animal-free innovation,
- provides scientific evidence (evidence-based) for policy development.
Read more on the website beyondanimaltesting.org.
The European Partnership for the Assessment of Risks from Chemicals (PARC) was launched in Paris in May 2022. PARC aims to develop a next-generation chemical risk assessment to protect human health and the environment as part of a "One Health" approach.
The partnership will help support the European Union’s Chemicals Strategy for Sustainability, paving the way for the zero pollution ambition announced in the European Green Deal. The partnership involves almost 200 partners in 28 countries and EU agencies. This European initiative is coordinated by the French Agency for Food, Environmental and Occupational Health & Safety (ANSES) and funded by the European Commission’s Horizon Europe Funding Programme for Research and Innovation as well as the partnership members.
PARC builds on previous work, in particular the actions undertaken as part of the European Joint Programme HBM4EU (Human Biomonitoring for Europe) and work from different European projects and programmes, such as the EURION and ASPIS clusters, EU-ToxRisk and EuroMix. https://www.eu-parc.eu/
On 29 December 2022, President Biden signed into law the FDA Modernization Act 2.0. The bill essentially refutes the Federal Food, Drug, and Cosmetics Act of 1938, which mandated animal testing for every new drug development protocol.
The new Act amends the Federal Food, Drug, and Cosmetic Act by authorising companies and researchers developing new drugs to use "certain alternatives to animal testing, including cell-based assays and computer models, to investigate the safety and effectiveness of a drug".
The bill "also removes a requirement to use animal studies as part of the process to obtain a license for a biological product that is biosimilar or interchangeable with another biological product".
Link: FDA Modernization Act 2.0 (Available in English)
Hundreds of animal welfare organisations and cosmetic firms launched the European Citizens’ Initiative (ECI) "Save Cruelty-free Cosmetics - Commit to a Europe without Animal Testing" in January 2023.
Over 1.2 million European citizens signed this petition against the use of animal testing for cosmetics. The initiative is in response to the EU Cosmetics Regulation banning cosmetics testing on animals, which came into force in 2013 and which nonetheless allows certain ingredients to be tested on laboratory animals to ensure the safety of workers in the production process. It calls for steps to be taken toprotect and strengthen the cosmetics animal testing ban, transform EU chemicals legislation and modernise science in the EU by initiating legislative changes that:
- Guarantee that no cosmetics ingredients are tested on animals for any purpose at any time
- No new animal testing requirements in the context of chemicals legislation
- Commit to a legislative proposal plotting a roadmap to phase out all animal testing in the EU
The European Commission published a Communication in response to this Citizens’ Initiative. In it, the Commission sets out, among other things, that while the cosmetics animal testing ban remains fully applicable, there are cases where animal testing may still be necessary. A roadmap towards phasing out animal testing for chemical safety assessments will also be set up, in collaboration with stakeholders, experts and Member States.
Young TPI (Transition Programme for Innovation without the use of animals) became an independent foundation in 2023, having begun as a spin-off from the national programme TPI. Young TPI is a group of enthusiastic and motivated young professionals, PhDs and students with different study and career backgrounds. What connects them is their interest in the transition towards animal-free innovations and their ambition to contribute to the acceleration of the transition.
The board members are students and young researchers who are fully committed to advancing animal-free innovations. Their activities include organising networking events and contributing to scientific training and education. Link to Young TPI website (launch mid-2024)
In early 2023, the Netherlands National Committee for the protection of animals used for scientific purposes (NCad) published an unsolicited advisory report on the potential of using human tissue for research as an alternative to animal testing.
Human tissue is an important research and teaching resource. The possibility of using human tissue as a viable alternative to testing prompts the NCad to ask: what is the availability of human tissue for scientific research and teaching? And how can its availability and use be encouraged and simplified, to replace or complement the use of laboratory animals?
On 13 April, Arfan Ikram, the President of ZonMw, presented the ZonMw Knowledge Agenda on the Transition to Animal-Free Innovations to Piet Adema, Minister of Agriculture, Nature and Food Quality. ZonMw’s goal with this agenda is to encourage discussion in the field. The knowledge agenda is also the starting point for an ambitious, multi-year knowledge and innovation programme which will usher in the start of a new period with more valuable human-relevant research with minimal laboratory animal testing.
For this Knowledge Agenda, ZonMw consulted with nearly 60 academic and commercial researchers, regulators, bridging figures, funders, students and lecturers from various Dutch universities and institutions. The consultation sessions yielded a range of opportunities, obstacles and research questions. Eight key recommendations were made. They include increased investment in studies for the validation of animal-free models to demonstrate their scientific value and suitability and thereby promote their use. It is also necessary to foster innovations that allow researchers to answer more complex questions. Animal-free research should be integral to the education and training programmes for researchers and the importance of interdisciplinary and transdisciplinary research should be emphasised.
Knowledge Agenda on the Transition to Animal-Free Innovations | ZonMw
In May, the public hearing of the European Parliament’s Committee on Environment, Public Health and Food Safety (ENVI) will be held on the European Citizens’ Initiative (ECI) "Save Cruelty-free Cosmetics - Commit to a Europe without Animal Testing".
Ahead of this, several European research funders have published a joint statement: ‘Human and animal health, preservation of species and biodiversity, require the use of animals and of non-animal approaches in science’. In this statement, the French National Alliance for Life Sciences and Health (AVIESAN) and the Netherlands Organisation for Health Research and Development (ZonMw) call on European policymakers to bring crucially important biomedical science insights into political discussions on the use of animals for scientific research. This statement is supported by many other European research funders and organisations.
The NCad is developing a target image for the field of cardiovascular research in collaboration with the Dutch CardioVascular Alliance (DCVA). The key objective of this target image is the application of experimental models. These models are useful as predictors for cardiovascular patients. The models are also able to address research questions in the best possible way.
A decision was made to organise this target image under the auspices of the Dutch CardioVascular Alliance (DCVA), a network organisation that unites 22 partners, including research funders, medical and technical researchers, users and patients. The target image puts forward seven recommendations. The annex sets out specific proposals that can replace the animal models with human measurement models. At the same time, the limitations of both kinds of models are listed. Adviesrapport streefbeeld cardiovasculair onderzoek | Rapport | Nationaal Comité advies dierproevenbeleid (ncadierproevenbeleid.nl)
Target images on animal-free research are objectives that fields of expertise aim for, i.e. reducing the use of animals in research. The NCad introduces the concept for this Target Image in a recommendation for transition titled ‘phase out trials using animals and promote innovations that do not involve animals’. Various research domains can use this concept to develop their own target images. The NCad provides advice in this respect and follows developments in animal-free research closely in the process.
On 25 July, the European Commission published a Communication on the European Citizens’ Initiative ’Save Cruelty-free Cosmetics – Commit to a Europe without Animal Testing’. The European Commission’s response also focuses on initiatives that will accelerate the transition to animal-free innovations. The recommendations are in line with Dutch TPI policy.
The European Commission emphasises that the practice of animal experimentation can only be phased out when scientifically valid methods are able to replace particular animal procedures and sufficient good alternatives to animal testing are available. The European Commission’s commitments are focused on supporting the development, validation and implementation of animal-free methods that can reduce and replace animal testing.
In its response, the European Commission announced a roadmap for phasing out animal testing in statutory chemicals safety assessments, which will be developed jointly with stakeholders and Member States.
The European Commission has also broadly underlined the declaration which was signed by multiple international research funders and organisations and was drafted by ZonMw and the French National Alliance for Life Sciences and Health (AVIESAN).
Commission acts to accelerate phasing out of animal testing (europa.eu)
The 12th World Congress on Alternatives and Animal Use in the Life Sciences took place in Niagara Falls, Canada, in August 2023. The theme is REPLACE. REDUCE. REFINE. 3Rs OVER THE EDGE. The Netherlands will be one of the best represented countries, with 28 presentations and 29 posters complementing our strong participant presence.
The Netherlands’ contribution (by TPI partners and others) includes the TPI approach in the Netherlands, the Venture Challenge, the impact of research funders, VHP4Safety, education, Helpathons, BATI, Young TPI, target images and preregistration of animal experiments. The European Citizens’ Initiative (ECI) and the European Commission’s response to it are also prominently highlighted.
The World Congress on Alternatives and Animal Use in the Life Sciences (WC series) was established by the Alternatives Congress Trust in Baltimore, USA, in 1993 to bring together multidisciplinary stakeholders from academia, industry, government and non-profit sectors under one roof to advance the 3Rs — to reduce, refine and replace the use of animals in the life sciences. Since 1993, the WC series has been held biennially or triennially across the continents from the Americas to Europe and the Far East.
The NCad provided a new opinion in August 2023. in which it set out the considerations for prioritising certain animal tests for seeking or developing animal-free alternatives.
In 2021, the Netherlands National Committee for the protection of animals used for scientific purposes (NCad) decided to investigate whether it might be possible to prioritise which animal experiments should be replaced with NAMs (New Approach Methodologies) first. The NCad was particularly concerned with animal models with limited translational value (while the translation of the research results really matters), animal models that involve severe distress, and animal models with little relevance or ethically questionable goals.
The NCad is developing this opinion with useful criteria for prioritising the replacement and phasing out of animal models. The basis for this is a report on prioritising animal experiments for replacement, i.e. which criteria could be used to assess which animal models should be prioritised for the development of NAMs.
In October 2023, research project VitalTissue was awarded €1.5 million to establish a new infrastructure that will make vital human residual tissue available and usable for health research in the Netherlands. Over the next few years, ZonMw, together with the Ministry of Agriculture, Nature and Food Quality, the Ministry of Health, Welfare and Sport, the Ministry of Education, Culture and Science, Stichting Proefdiervrij (Foundation for Animal-free Research) and ETB-BISLIFE will fund this new VitalTissue infrastructure.
This funding will enable independent Dutch tissue bank ETB-BISLIFE to implement VitalTissue in its organisation. This will allow researchers in the near future to use residual tissue from operations for their research. In doing so, VitalTissue contributes to results that are more translatable to humans and to the transition to animal-free innovations.
The Ministry of Agriculture, Nature and Food Quality, in partnership with the Ministry of Education, Culture and Science, the European Commission and several Member States, has submitted a proposal for the European Research Area (ERA) Policy Agenda for the period 2025-2027. This policy instrument is aimed at harmonising research policies and programmes of EU Member States to enhance EU-wide cooperation on specific topics.
This proposal, which TPI is spearheading, focuses on cooperation and prioritisation between participating countries, including in the areas of development and validation of animal-free innovations, education, infrastructure and promoting awareness and transparency. Formal acceptance of the proposal is still awaited, with the Member States set to make their decision at a later date.
The Netherlands Heart Institute Preclinical Trials (PCT) has acquired follow-up funding from the Ministry of Agriculture, Nature and Food Quality. Maintaining a registry of this nature helps to avoid duplicating existing research and enhances the overall quality and reliability of research using laboratory animals, thereby contributing to the reduction of animal testing.
The Netherlands Heart Institute was previously granted funding for PCT. This follow-up funding is intended to ensure the sustainable continuation, enhancement and further development of PCT as an international platform. Through this measure the Ministry is acting on the House of Representatives’ demand for the registration of each animal experiment.
Read more about the Netherlands Heart Institute’s Preclinical Trials (PCT).
A working group of experts is developing the Target Image Immunology for immunological research, at the NCad’s request. The Target Image will be presented in December. The aim of the Immunology Working Group is to develop a roadmap that will energise the transition towards the use of NAMs in immunology.
Target images on animal-free research are objectives that fields of expertise aim for, i.e. reducing the use of animals in research. The NCad introduced the concept for this Target Image in a recommendation for transition titled ‘phase out trials using animals and promote innovations that do not involve animals’. Various research domains can use this concept to develop their own target images. The NCad provides advice in this respect and follows developments in animal-free research closely in the process.
Immunological research is aimed at understanding molecular and cellular processes that underlie pathologies of human diseases as well as infections, while also focusing on developing interventions to treat or prevent these diseases and infections. Non-animal, or new approach methodologies (NAMs), will allow us to investigate immunological processes in much more detail and with more relevance for human diseases and infections.
On 11-12 December 2023, the European Commission organised a workshop on the Commission roadmap towards ultimately phasing out animal testing for chemical risk assessments. The main objective was to engage with relevant stakeholders to explore ways to promote the integration of animal-free testing methods in EU chemicals legislation. The Commission roadmap towards ultimately phasing out animal testing for chemical risk assessments is expected to be finalised at the end of 2025, in the first quarter of the mandate of the next Commission.
Over the next two years, the Commission will engage with stakeholders and experts to develop this roadmap. It will include milestones and specific actions that need to be completed before animal-free EU chemicals legislation can be realised. Animal-free testing methods will be analysed: what critical requirements should testing methods meet, how should an animal-free regulatory system be designed and, ultimately, what legal and other changes are necessary? The programme office and several TPI partners will participate in these discussions.
The National Growth Fund is investing 124.5 million euros in a new national Centre for Animal-free Biomedical Translation. The aim of the centre is to promote safer, more effective and better medical treatments with fewer animals.
The Centre for Animal-free Biomedical Translation (Centrum voor Proefdiervrije Biomedische Translatie, CPBT) will accelerate the transition to animal-free biomedical innovations through the contribution of the National Growth Fund (NGF). This will bring economic and societal benefits: better medicines and reduced animal testing. With funding for ten years, this investment offers the Netherlands the opportunity to become a global pioneer in the transition to animal-free innovation, one of the ambitions of the Transition Programme for Innovation without the use of animals (TPI).
CPBT, together with a large number of national and international parties, will establish a centre to accelerate the development and commercialisation of animal-free innovations. CPBT will initially focus on research into drugs for patients with ALS, cystic fibrosis, osteoarthritis/rheumatism or asthma/COPD.
The aim is to implement the developed animal-free testing methods, tools and expertise together with researchers and companies. The new centre will also provide education, training, advice and support. This will strengthen the acceptance and use of animal-free biomedical innovations. The end goal is to distribute this knowledge on a wide scale, for these four research areas as well as beyond. It will be an integrated national programme that accelerates the transition to animal-free innovation and strengthens the economic competitiveness of the Netherlands.
The Centre for Animal-free Biomedical Translation (CPBT) is an initiative of Utrecht University, UMC Utrecht, HU University of Applied Sciences Utrecht and the National Institute for Public Health and the Environment (RIVM).
On 28 March, Arfan Ikram, the President of ZonMw, presented the research report “Better Science through More Transparency; Pilot study on stimulating transparent laboratory animal research” to Robbert Dijkgraaf, the Minister of Education, Culture and Science.
The research report sets out the results of a study conducted by ZonMw over the past 3.5 years, and commissioned by the Dutch Ministry of Education, Culture and Science, on transparency methods regarding animal research, which also makes concrete recommendations to various stakeholders with regard to laboratory animal research. Based on the findings of the report, ZonMw plans to engage with other research funders regarding the possible establishment of new grant conditions relating specifically to transparent research involving laboratory animals.
In April 2024, ZonMw launched its new four-year programme ‘More Knowledge with Fewer Animals’ (Dutch acronym: MKMD), with continued funding by the Ministry of Agriculture, Nature and Food Quality. The new programme draws its inspiration from the ZonMw Knowledge Agenda on the Transition to Animal-Free Innovations and the insights derived for that purpose.
A key aspect of the new programme is the validation of techniques that do not involve the use of laboratory animals via public-private collaborations, to promote their widespread adoption. Also, multiple strategies are being employed in an effort to alter the mindset regarding animal testing. These include providing incentives within the Off Road programme for successful applications for funding for research which is entirely animal-free. Furthermore, grants are awarded to research groups that are keen to learn how to implement a particular animal-free innovation from a group or lab with proven expertise in this field. Additionally, as part of this programme, ZonMw is engaged in the development of the NAM Navigator, an online knowledge portal which will provide accessible information on the funding, development, validation and qualification of animal-free models to a wide scientific audience.
Over the last 24 years, ZonMw has been driving the development and implementation of animal-free innovations.
MKMD-Programmatekst-2024-2028-vs9-Final-cover.pdf (zonmw.nl)
The Landscape New Approach Methodologies (NAMs) for the safety assessment of pharmaceutical products provides a current overview of which steps can be taken to implement NAMs in regulatory frameworks for pharmaceutical products.
New Approach Methodologies (NAMs) can reduce animal testing for the safety assessment of pharmaceutical products. However, implementing them in guidelines is more complex and involves many stakeholders. The publication also shows which body is involved in each step. Gaining insight into these steps is essential to facilitate the implementation of NAMs. The Landscape also provides examples of funding and research projects for NAMs as well as identifying key trends and networks that are essential in facilitating the acceptance of NAMs for pharmaceutical product safety assessment.
The Landscape was developed in collaboration with the Regulatory Science CBG-MEB, which specialises in pharmaceutical products and implementation of NAMs. Landscape New Approach Methodologies (NAMs) for the safety assessment of pharmaceutical products | RIVM
Young TPI will present their Manifesto on 18 April. By endorsing this manifesto, the members of Young TPI declare their commitment to promoting the transition towards animal-free innovation. The document outlines Young TPI’s principles, objectives and strategy for achieving a future where innovative research without the use of animals is the norm.
Guided by six key themes, Young TPI charts the future path for young researchers and all stakeholders in the transition towards animal-free innovation:
1. Technologies. Developing and Implementing Animal-Free Innovations
2. Transition Science. Guiding the Transition Process
3. Policy Approach. Governing the Transition
4. Education. Teaching the New Way of Thinking and Doing
5. Interdisciplinarity. Facilitating Collaboration
6. The Bigger Picture. Addressing Overarching Questions
The manifesto was written with input from various brainstorm and feedback sessions with Young TPI members.
On 19 June, more than 170 people from the various networks of animal testing and animal-free innovation gathered in Media Plaza of the Jaarbeurs in Utrecht. More than 70 people also joined online. Together, the participants explored the best way forward for human-based biomedical basic and translational science.
Lectures were delivered by Hans Clevers (Roche) and Thomas Hartung (John Hopkins) and there were sessions with panel discussions that yielded multiple questions and insights on the 3Rs and NAMs (New Approach Methodologies). The various sectors were well represented; by researchers working with NAMs and 3Rs (Replacement, Reduction and Refinement of animal testing), participants from the regulatory field, policymakers, NGOs and industry figures. Both national and international networks were represented. The international representation consisted largely of people involved in the IMP3ROVE network. Many young professionals were also present at the event.
The symposium was organised by TPI, the 3Rs Centre Utrecht, the Netherlands National Committee for the protection of animals used for scientific purposes (NCad) and TPI Utrecht.
See also:
In September 2024, the NCad publishes an evaluation report on the implementation of its 2016 advice. The conclusion is: 'The transition to animal-free research is progressing steadily both in the Netherlands and internationally, and there is movement across all areas of scientific research. At the same time, there are still aspects that remain underexposed that could give the transition a further boost.
The evaluation was published to assess the progress of the transition and the impact of the 2016 transition advice. In this advice, the NCad made recommendations to accelerate the transition to animal-free research and reduce the use of laboratory animals.
Also see:
On 25 September, TPI organises the very first TPI lab tour together with Leiden University Medical Centre (LUMC). With these lab tours, the Transition Programme for Innovation without the use of animals (TPI) aims to give people a tangible insight into the development of animal-free innovations and to allow them to meet the researchers who bring the transition a little bit closer every day.
The participants represent several sectors: science, NGOs, research funding bodies and donors. They share the same interest: research models without animal experiments and the transition to animal-free innovations. The participants were shown a lab with 3D skin models, 3D brain models and the Central Animal Facility.
Also see:
Hollandbio is joining in January 2025 the TPI partner programme. With the addition of Hollandbio, TPI now also has a representative from the biotechnological sector, which offers opportunities to implement non-animal models in practice.
Various organisations have joined forces in this partner programme to accelerate the transition to animal-free innovations.
Also see:
In February 2025, the 3Rs Center Utrecht publishes an advisory report on access to expertise in New Approach Methodologies (NAMs). This report, commissioned by TPI/LVVN, shows, among other things, that there is a great need for more expertise on NAMs and, related to this, for NAMs experts. The results have been compiled in an advisory report to TPI/LVVN.
Also see:
- The advisory report: Access to NAMs expertise (in Dutch)
- Website 3Rs Centre
ZonMw launches in April 2025 the NAM Navigator: a knowledge portal to navigate you through information on the development, standardization, validation and acceptance of New Approach Methodologies (NAM). It acts as an online guide providing specific information needed in each of these steps, thereby increasing the broad use of animal-free innovations.
The NAM Navigator has been commissioned by the Dutch Ministry of Agriculture, Fisheries, Food Security and Nature (TPI).
Also see:
On World Laboratory Animal Day 24 April 2025), a team of scientists named HeartSmart wins the anniversary edition of the Proefdiervrij Venture Challenge. With the prize money of 25,000 euros, the team will bring their animal-free heart model to market. The prize was presented in the presence of scientists, entrepreneurs and students during the annual Proefdiervrij Event, this year at a very appropriate location: Corpus in Leiden.
Also see:
The 3Rs Centre Utrecht launches the Basement Membrane Extract (BME)-free Database in May 2025. For animal-free innovations such as organoids and pluripotent stem cells, researchers are still partly dependent on materials derived from animals. These materials are necessary for the cells to grow and differentiate into, for example, brain cells or skin cells.
Also see:
The Executive Board appoints Anne Kienhuis as Professor of Toxicology in Transition at the Faculty of Veterinary Medicine of Utrecht University with effect from 1 June 2025. The chair contributes to various transitions in toxicology, such as the transition to animal-free innovations. Anne Kienhuis: “Our goal is to reliably assess the safety of chemical substances and pharmaceuticals without animal testing.”
Also see:
The EU Council reaches a political agreement on a council recommendation to adopt the European Research Area (ERA) Policy Agenda 2025–2027. This roadmap also addresses, among other key challenges, the transition towards animal-free innovation.
The Netherlands, in close collaboration with the European Commission, played a key role in drafting this important initiative and will act as co-chair. This research agenda is an enormous opportunity to advance NAMs for use in biomedical research and testing of medicinal products and medical devices.
Also see:
Within the Human Measurement Models program, six new projects will conduct research into the further development of human measurement models. The Collaborating Health Funds (Samenwerkende Gezondheidsfondsen SGF), ZonMw, and Top Sector Life Sciences & Health (Health~Holland) are jointly financing the projects.
Human measurement models are research models that take humans as their starting point, such as human cells and tissues on a chip or computer models that use human data. This makes it possible to make research more predictable and faster applicable for patients. In addition, the use of these models will make science less dependent on animal testing.
Also see:
As of 1 July, toxicologist Mirjam Luijten from the Dutch National Institute for Public Health and the Environment (RIVM) starts as professor by special appointment at the Leiden Academic Centre for Drug Research (LACDR).
The central theme of the chair, which is funded by RIVM, is what’s known as ‘next-generation risk assessment’. This approach aims to assess the safety of chemical substances for humans using a combination of modern testing methods – from computer models to lab-based (in vitro) tests. For LACDR and Leiden University, the collaboration brings in more knowledge about regulatory processes for chemical substances and offers valuable opportunities to translate fundamental research into practical tools for policy.
Also see:
hDMT becomes in July 2025 the 12th partner of the TPI partner programma. With the addition of hDMT, TPI welcomes a consortium, consisting of the hDMT foundation and 16 partner organizations, including (technical) universities, university medical centers, a university of applied sciences and a knowledge and innovation institute. This offers opportunities to implement non-animal models in practice.
Various organisations have joined forces in this partner programme to accelerate the transition to animal-free innovations.
Also see:
On 7 July 2025 the Centre for Animal-free Biomedical Translation, supported by the Dutch National Growth Fund, is officially launched under its new name: Ombion Centre for Animal-free Biomedical Translation.
The launch of Ombion took place during a festive event in the presence of many guests at the Life Sciences Incubator building at Utrecht Science Park. The opening of the centre and the unveiling of the new name and logo was performed by Marten van den Berg, Director General Agriculture of the Ministry of Agriculture, Fisheries, Food Security and Nature, together with Daniela Salvatori, Ombion's Scientific Director ad interim.
The Ministry of Agriculture, Fisheries, Food Security and Nature originally submitted the CPBT National Growth Fund proposal, which was granted last year (124,5 M euro of which 55 milj unconditionally). This has now resulted in the establishment of the centre.
Also see:
Two unique projects have been honoured in the Create2Solve Phase 2 grant round: one for the development of an in vitro model for arthritis and one for the development and standardisation of complex culture methods with animal-free reagents. The 2 consortia, which include companies, will now each receive €1 million to work on these subjects.
With the Create2Solve instrument, ZonMw stimulates the development of innovative, animal-free methods through public-private partnerships. The involvement of commercial/industrial partners is particularly important as a starting point within Create2Solve, to encourage these promising models to become not only scientifically but also commercially valuable.
Also see:
- News Sustainable Breakthrough: Two ground-breaking Create2Solve projects honoured
- Create2Solve is part of the programma More Knowledge with Fewer Animals
News

Two NWO Perspective projects will contribute to more research without laboratory animals
No fewer than twelve consortia will be able to start their research projects aimed at developing technological innovations thanks ...
15-12-20259:51Image: ShutterstockRead more
TPI Lab Tour Amsterdam: TPI Lab Tour Amsterdam: human and animal research models in practice
On 10 November, we organised the second TPI Lab Tour Amsterdam in partnership with TPI. Four laboratories and the Amsterdam ...
27-11-202512:22Image: TPIRead more
Animal-free Research Helpathon: Everyone’s an Expert
What do you consider important regarding the improvement of health and safety research for people, animals and the environment? ...
27-11-202511:27Image: TPIRead more
Ombion Centre for Animal-free Biomedical Translation celebrates launch and site opening
Today, the Centre for Animal-free Biomedical Translation, supported by the Dutch National Growth Fund, was officially launched ...
07-07-202516:34Read more
TPI welcomes new partner hDMT
The TPI partner programme is pleased to announce that hDMT is joining as a partner. With the addition of hDMT, TPI welcomes a ...
03-07-202515:00Read more
Next step in accelerating the transition towards animal-free innovation in Europe
EU Council endorses the European research area policy agenda for the next three years.
27-05-202515:35Read more